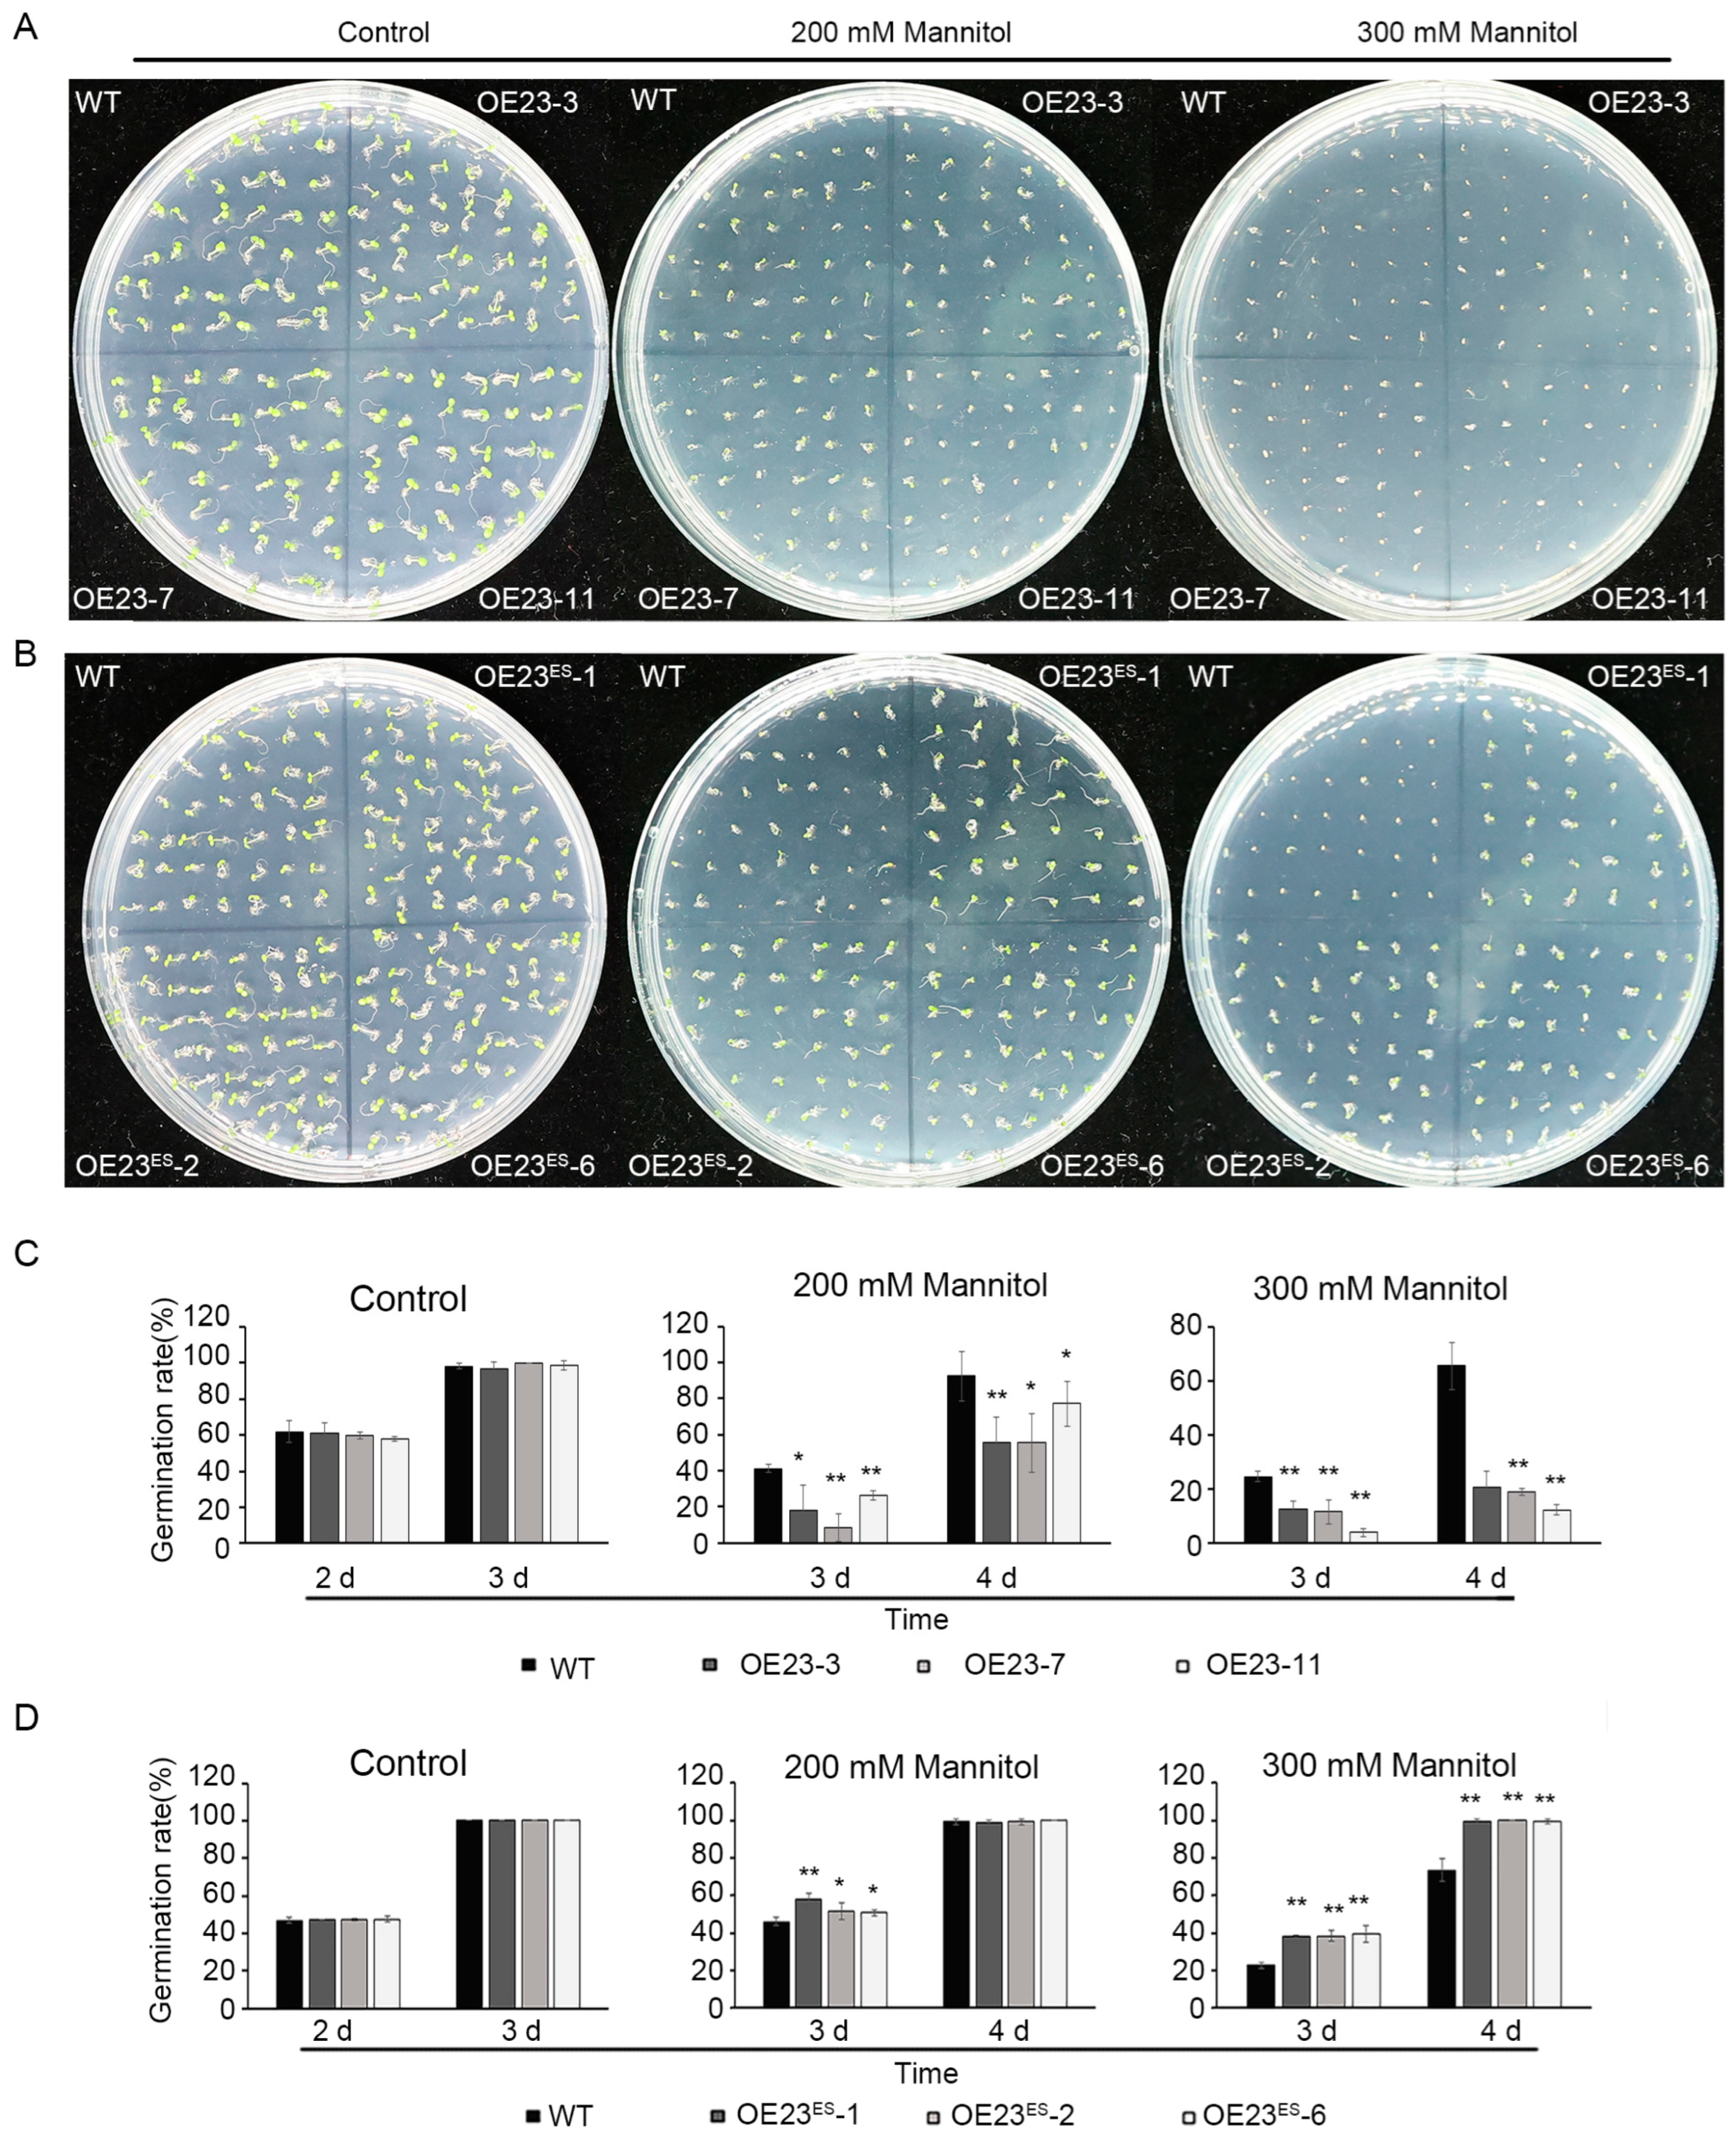
Plants 13 03452 g006

Alternative Splicing of PheNAC23 from Moso Bamboo Impacts Flowering Regulation and Drought Tolerance in Transgenic Arabidopsis
Abstract
1. Introduction
2. Results
2.1. Identification and Phylogenetic Analysis of PheNACs
2.2. PheNAC23 Locus Expressed Two Distinct Transcripts
2.3. PheNAC23 and PheNAC23ES Had Different Subcellular Localization and Transcriptional Activity
2.4. PheNAC23ES Formed a Heterodimer with PheNAC23
2.5. PheNAC23 and PheNAC23ES Have Opposite Functions in Regulating Flowering
2.6. PheNAC23 and PheNAC23ES Have Opposite Functions in Drought Stress Response
3. Discussion
4. Materials and Methods
4.1. Identification of PheNACs in Moso Bamboo and Other Species
4.2. Phylogenetic Tree Construction and Sequence Analysis
4.3. Plant Material and Treatments
4.4. Gene Expression Analysis PheNAC23 and PheNAC23ES
4.5. PheNAC23 Gene Cloning, Subcellular Localization and Transcriptional Activation
4.6. Overexpression of PheNAC23 and PheNAC23ES in Arabidopsis
4.7. Y2H and BiFC Assays
Supplementary Materials
Author Contributions
Funding
Institutional Review Board Statement
Informed Consent Statement
Data Availability Statement
Conflicts of Interest
References
- Li, Y.M.; Feng, P.F. Bamboo Resources in China Based on the Ninth National Forest Inventory Data. World Bamboo Ratt. 2019, 17, 46–48. [Google Scholar]
- Gao, D.J.; Wu, X.A.; Ding, Y.F.; Hu, J.L.; Li, Q.; Peng, A.J.; Xiao, Y.J. The influence of abnormal weather events on the growth of bamboo shoot forest and the disaster reduction technology. Hunan For. Sci. Technol. 2020, 47, 58–63. [Google Scholar]
- Peng, Z.H.; Lu, Y.; Li, L.; Zhao, Q.; Feng, Q.; Gao, Z.; Lu, H.; Hu, T.; Yao, N.; Liu, K.; et al. The draft genome of the fast-growing non-timber forest species moso bamboo (Phyllostachys heterocycla). Nat. Genet. 2013, 45, 456–461. [Google Scholar] [CrossRef] [PubMed]
- Yamaguchi-Shinozaki, K.; Shinozaki, K. Transcriptional regulatory networks in cellular responses and tolerance to dehydration and cold stresses. Annu. Rev. Plant Biol. 2006, 57, 781–803. [Google Scholar] [CrossRef]
- Tran, L.S.P.; Nishiyama, R.; Yamaguchi-Shinozaki, K.; Shinozaki, K. Potential utilization of NAC transcription factors to enhance abiotic stress tolerance in plants by biotechnological approach. GM Crop. 2010, 1, 32–39. [Google Scholar] [CrossRef]
- Ooka, H.; Satoh, K.; Doi, K.; Nagata, T.; Otomo, Y.; Murakami, K.; Matsubara, K.; Osato, N.; Kawai, J.; Carninci, P.; et al. Comprehensive analysis of NAC family genes in Oryza sativa and Arabidopsis thaliana. DNA Res. 2003, 10, 239–247. [Google Scholar] [CrossRef]
- Puranik, S.; Sahu, P.P.; Srivastava, S.P.; Prasad, M. NAC proteins: Regulation and role in stress tolerance. Trends Plant Sci. 2012, 17, 369–381. [Google Scholar] [CrossRef]
- Ernst, H.A.; Olsen, A.N.; Skriver, K.; Larsen, S.; Lo Leggio, L. Structure of the conserved domain of ANAC, a member of the NAC family of transcription factors. EMBO Rep. 2004, 5, 297–303. [Google Scholar] [CrossRef]
- Chen, Q.F.; Wang, Q.; Xiong, L.Z.; Lou, Z.Y. A structural view of the conserved domain of rice stress-responsive NAC1. Protein Cell 2011, 2, 55–63. [Google Scholar] [CrossRef]
- Elizebeth, M.I.; Pinky, A. May the fittest protein evolve: Favoring the plant-specific origin and expansion of NAC transcription factors. BioEssays 2018, 40, 1800018. [Google Scholar] [CrossRef]
- Kim, S.G.; Kim, S.Y.; Park, C.M. A membrane-associated NAC transcription factor regulates salt-responsive flowering via FLOWERING LOCUS T in Arabidopsis. Planta 2007, 226, 647–654. [Google Scholar] [CrossRef] [PubMed]
- Yoo, S.Y.; Kim, Y.; Kim, S.Y.; Lee, J.S.; Ahn, J.H. Control of flowering time and cold response by a NAC-domain protein in Arabidopsis. PLoS ONE 2007, 2, e642. [Google Scholar] [CrossRef] [PubMed]
- Fang, Y.J.; Xie, K.; Xiong, L.Z. Conserved miR164-targeted NAC genes negatively regulate drought resistance in rice. J. Exp. Bot. 2014, 65, 2119–2135. [Google Scholar] [CrossRef]
- Mannai, E.Y.; Akabane, K.; Hiratsu, K.; Satoh-Nagasawa, N.; Wabiko, H. The NAC transcription factor gene OsY37 (ONAC011) promotes leaf senescence and accelerates heading time in rice. Int. J. Mol. Sci. 2017, 18, 2165. [Google Scholar] [CrossRef]
- Chen, M.X.; Zhang, K.L.; Zhang, M.; Das, D.; Fang, Y.M.; Dai, L.; Zhang, J.H.; Zhu, F.Y. Alternative splicing and its regulatory role in woody plants. Tree Physiol. 2020, 40, 1475–1486. [Google Scholar] [CrossRef]
- Paola, P.; Grillo, S.; Batelli, G. Alternative splicing in plant abiotic stress responses. Biochem. Soc. Trans. 2020, 48, 2117–2126. [Google Scholar] [CrossRef]
- Seo, P.J.; Hong, S.Y.; Kim, S.G.; Park, C.M. Competitive inhibition of transcription factors by small interfering peptides. Trends Plant Sci. 2011, 16, 541–549. [Google Scholar] [CrossRef] [PubMed]
- Tognacca, R.S.; Rodríguez, F.S.; Aballay, F.E.; Cartagena, C.M.; Servi, L.; Petrillo, E. Alternative splicing in plants: Current knowledge and future directions for assessing the biological relevance of splice variants. J. Exp. Bot. 2022, 74, 2251–2272. [Google Scholar] [CrossRef] [PubMed]
- Li, Q.Z.; Lin, Y.C.; Sun, Y.H.; Song, J.; Chen, H.; Zhang, X.H.; Sederoff, R.R.; Chiang, V.L. Splice variant of the SND1 transcription factor is a dominant negative of SND1 members and their regulation in Populus trichocarpa. Proc. Natl. Acad. Sci. USA 2012, 109, 14699–14704. [Google Scholar] [CrossRef]
- Mathew, I.E.; Das, S.; Mahto, A.; Agarwal, P. Three rice NAC transcription factors heteromerize and are associated with seed size. Front. Plant Sci. 2016, 7, 1638. [Google Scholar] [CrossRef]
- Pan, J.; Wang, H.R.; Cheng, Q. Cloning and functional analysis of PtATAF1-1 transcription factor gene of Populus trichocarpa. Mol. Plant Breed. 2021, 19, 4343–4349. [Google Scholar] [CrossRef]
- Zhang, J.; Li, L.; Huang, L.; Zhang, M.M.; Chen, Z.Y.; Zheng, Q.S.; Zhao, H.Y.; Chen, X.; Jiang, M.Y.; Tan, M.P. Maize NAC-domain retained splice variants act as dominant negatives to interfere with the full-length NAC counterparts. Plant Sci. 2019, 289, 110256. [Google Scholar] [CrossRef] [PubMed]
- Wang, H.L.; Zhang, Y.; Wang, T.; Yang, Q.; Yang, Y.L.; Li, Z.; Li, B.S.; Wen, X.; Li, W.Y.; Yin, W.L.; et al. An alternative splicing variant of PtRD26 delays leaf senescence by regulating multiple NAC transcription factors in Populus. Plant Cell 2021, 33, 1594–1614. [Google Scholar] [CrossRef]
- Hou, D.; Zhao, Z.Y.; Hu, Q.T.; Li, L.; Vasupalli, N.; Zhuo, J.; Zeng, W.; Wu, A.M.; Lin, X.C. PeSNAC-1 a NAC transcription factor from moso bamboo (Phyllostachys edulis) confers tolerance to salinity and drought stress in transgenic rice. Tree Physiol. 2020, 40, 1792–1806. [Google Scholar] [CrossRef]
- Xie, L.H.; Cai, M.M.; Li, X.Y.; Zheng, H.F.; Xie, Y.L.; Cheng, Z.C.; Gao, J. Overexpression of PheNAC3 from moso bamboo promotes leaf senescence and enhances abiotic stress tolerance in Arabidopsis. PeerJ 2020, 8, e8716. [Google Scholar] [CrossRef] [PubMed]
- Wang, L.L.; Zhao, H.S.; Chen, D.; Li, L.; Sun, H.; Lou, Y.; Gao, Z.M. Characterization and primary functional analysis of a bamboo NAC gene targeted by miR164b. Plant Cell Rep. 2016, 35, 1371–1383. [Google Scholar] [CrossRef]
- Xie, L.H.; Tong, Y.P.; Cai, M.M.; Cheng, Z.C.; Gao, J. Overexpression of PheNAC1 from moso bamboo negatively regulate salt resistance in Arabidopsis. Mol. Plant Breed. 2023, 21, 4640–4649. [Google Scholar] [CrossRef]
- Gao, J.; Zhang, Y.; Zhang, C.; Qi, F.; Li, X.; Mu, S.; Peng, Z. Characterization of the floral transcriptome of moso bamboo (Phyllostachys edulis) at different flowering developmental stages by transcriptome sequencing and RNA-Seq analysis. PLoS ONE 2014, 9, e98910. [Google Scholar] [CrossRef] [PubMed]
- Fang, Y.J.; You, J.; Xie, K.B.; Xie, W.B.; Xiong, L.Z. Systematic sequence analysis and identification of tissue-specific or stress-responsive genes of NAC transcription factor family in rice. Mol. Genet. Genom. 2008, 280, 547–563. [Google Scholar] [CrossRef]
- Ren, Y.J.; Yang, S.W.; Wu, D.X.; Huang, C.X.; Guan, Y.R.; Miao, Y. Leaf senescence characteristics and the screen and identification of leaf senescence associated genes in moso bamboo. J. Fujian Agric. For. Univ. 2017, 46, 630–640. [Google Scholar] [CrossRef]
- Michael, K.J.; Trine, K.; Michael, M.N.; Pernille, G.; Klaus, P.; Charlotte, O.; Karen, S. The Arabidopsis thaliana NAC transcription factor family: Structure–function relationships and determinants of ANAC019 stress signaling. Biochem. J. 2010, 426, 183–196. [Google Scholar] [CrossRef]
- Zhao, H.S.; Gao, Z.M.; Wang, L.; Wang, J.L.; Wang, S.B.; Fei, B.H.; Chen, C.H.; Shi, C.C.; Liu, X.C.; Zhang, H.L.; et al. Chromosome-level reference genome and alternative splicing atlas of moso bamboo (Phyllostachys edulis). GigaScience 2018, 7, giy115. [Google Scholar] [CrossRef] [PubMed]
- Shang, X.D.; Cao, Y.; Ma, L.G. Alternative splicing in plant genes: A means of regulating the environmental fitness of plants. Int. J. Mol. Sci. 2017, 18, 432. [Google Scholar] [CrossRef]
- Wang, T.T.; Wang, H.Y.; Cai, D.W.; Gao, Y.B.; Zhang, H.X.; Wang, Y.S.; Lin, C.T.; Ma, L.Y.; Gu, L.F. Comprehensive profiling of rhizome-associated alternative splicing and alternative polyadenylation in moso bamboo (Phyllostachys edulis). Plant J. 2017, 91, 684–699. [Google Scholar] [CrossRef]
- Li, L.; Cheng, Z.C.; Ma, Y.J.; Bai, Q.S.; Li, X.Y.; Cao, Z.H.; Wu, Z.N.; Gao, J. The association of hormone signaling genes, transcription and changes in shoot anatomy during moso bamboo growth. Plant Biotechnol. J. 2018, 16, 72–85. [Google Scholar] [CrossRef]
- Li, L.; Shi, Q.; Hou, D.; Cheng, Z.C.; Li, J.; Ma, Y.J.; Li, X.P.; Mu, S.H.; Gao, J. Transcriptome analysis of alternative splicing in different moso bamboo tissues. Acta Physiol. Plant. 2018, 40, 89. [Google Scholar] [CrossRef]
- Corbesier, L.; Vincent, C.; Jang, S.; Fornara, F.; Fan, Q.; Searle, I.; Giakountis, A.; Farrona, S.; Gissot, L.; Turnbull, C.; et al. FT protein movement contributes to long-distance signaling in floral induction of Arabidopsis. Science. 2007, 316, 1030–1033. [Google Scholar] [CrossRef]
- Michaels, S.D.; Amasino, R.M. FLOWERING LOCUS C encodes a novel MADS domain protein that acts as a repressor of flowering. Plant Cell 1999, 11, 949–956. [Google Scholar] [CrossRef]
- Helliwell, C.A.; Wood, C.C.; Robertson, M.; Peacock, W.J.; Dennis, E.S. The Arabidopsis FLC protein interacts directly in vivo with SOC1 and FT chromatin and is part of a high-molecular-weight protein complex. Plant J. 2006, 46, 183–192. [Google Scholar] [CrossRef]
- Lee, H.; Suh, S.S.; Park, E.; Cho, E.; Ahn, J.H.; Kim, S.G.; Lee, J.S.; Kwon, Y.M.; Lee, I. The AGAMOUS-LIKE 20 MADS domain protein integrates floral inductive pathways in Arabidopsis. Gene Dev. 2000, 14, 2366–2376. [Google Scholar] [CrossRef]
- Sha, G.; Shen, X.; Wu, Z.N.; Xu, X.C.; Xu, X.; Tan, Y.P.; Liu, X.Q.; Tang, X.Y.; Wang, C.T.; Qin, Y.H. Alternative splicing of OsCYL4 controls drought resistance via regulating water loss and reactive oxygen species scavenging in rice. Rice Sci. 2023, 31, 1–5. [Google Scholar] [CrossRef]
- Conesa, A.; Götz, S.; Garcíagómez, J.M.; Terol, J.; Talón, M.; Robles, M. Blast2GO: A universal tool for annotation, visualization and analysis in functional genomics research. Bioinformatics 2005, 21, 3674–3676. [Google Scholar] [CrossRef]
- Thompson, J.D.; Gibson, T.J.; Plewniak, F.; Jeanmougin, F.; Higgins, D.G. The CLUSTAL_X windows interface: Flexible strategies for multiple sequence alignment aided by quality analysis tools. Nucleic Acids Res. 1997, 25, 4876–4882. [Google Scholar] [CrossRef]
- Hu, B.; Jin, J.P.; Guo, A.Y.; Zhang, H.; Luo, J.C.; Gao, G. GSDS 2.0: An upgraded gene feature visualization server. Bioinformatics 2015, 31, 1296–1297. [Google Scholar] [CrossRef] [PubMed]
- Bailey, T.L.; Boden, M.; Buske, F.A.; Frith, M.; Grant, C.E.; Clementi, L.; Ren, J.Y.; Li, W.W.; Noble, W.S. MEME SUITE: Tools for motif discovery and searching. Nucleic Acids Res. 2009, 37, W202–W208. [Google Scholar] [CrossRef]
- Fan, C.J.; Ma, J.M.; Guo, Q.R.; Li, X.T.; Wang, H.; Lu, M.Z. Selection of reference genes for quantitative real-time PCR in bamboo (Phyllostachys edulis). PLoS ONE 2013, 8, e56573. [Google Scholar] [CrossRef]
- Livak, K.J.; Schmittgen, T.D. Analysis of relative gene expression data using real-time quantitative PCR and the 2(-Delta Delta C(T)) method. Methods 2001, 25, 402–408. [Google Scholar] [CrossRef] [PubMed]
- Sparkes, I.A.; Runions, J.; Kearns, A.; Hawes, C. Rapid, transient expression of fluorescent fusion proteins in tobacco plants and generation of stably transformed plants. Nat. Protoc. 2006, 1, 2019–2025. [Google Scholar] [CrossRef]
- Cui, X.W.; Zhang, Y.; Qi, F.Y.; Gao, J.; Chen, Y.W.; Zhang, C.L. Overexpression of a moso bamboo (Phyllostachys edulis) transcription factor gene PheWRKY1 enhances disease resistance in transgenic Arabidopsis thaliana. Botany 2013, 91, 486–494. [Google Scholar] [CrossRef]
- Clough, S.J.; Bent, A.F. Floral dip: A simplified method for Agrobacterium-mediated transformation of Arabidopsis thaliana. Plant J. 1998, 16, 735–743. [Google Scholar] [CrossRef]

Disclaimer/Publisher’s Note: The statements, opinions and data contained in all publications are solely those of the individual author(s) and contributor(s) and not of MDPI and/or the editor(s). MDPI and/or the editor(s) disclaim responsibility for any injury to people or property resulting from any ideas, methods, instructions or products referred to in the content. |
© 2024 by the authors. Licensee MDPI, Basel, Switzerland. This article is an open access article distributed under the terms and conditions of the Creative Commons Attribution (CC BY) license (https://creativecommons.org/licenses/by/4.0/).
Share and Cite
Xie, L.; Li, X.; Yao, P.; Cheng, Z.; Cai, M.; Liu, C.; Wang, Z.; Gao, J. Alternative Splicing of PheNAC23 from Moso Bamboo Impacts Flowering Regulation and Drought Tolerance in Transgenic Arabidopsis. Plants 2024, 13, 3452. https://doi.org/10.3390/plants13233452
Xie L, Li X, Yao P, Cheng Z, Cai M, Liu C, Wang Z, Gao J. Alternative Splicing of PheNAC23 from Moso Bamboo Impacts Flowering Regulation and Drought Tolerance in Transgenic Arabidopsis. Plants. 2024; 13(23):3452. https://doi.org/10.3390/plants13233452
Chicago/Turabian StyleXie, Lihua, Xiangyu Li, Pengqiang Yao, Zhanchao Cheng, Miaomiao Cai, Chunyang Liu, Zhe Wang, and Jian Gao. 2024. "Alternative Splicing of PheNAC23 from Moso Bamboo Impacts Flowering Regulation and Drought Tolerance in Transgenic Arabidopsis" Plants 13, no. 23: 3452. https://doi.org/10.3390/plants13233452
APA StyleXie, L., Li, X., Yao, P., Cheng, Z., Cai, M., Liu, C., Wang, Z., & Gao, J. (2024). Alternative Splicing of PheNAC23 from Moso Bamboo Impacts Flowering Regulation and Drought Tolerance in Transgenic Arabidopsis. Plants, 13(23), 3452. https://doi.org/10.3390/plants13233452





